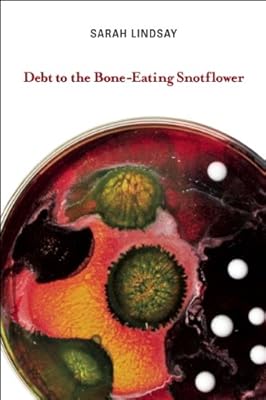
Debt to the Bone-Eating Snotflower

Readers also enjoyed
24 books
Careless People: A Cautionary Tale of Power, Greed, and Lost Idealism

Punderdome: A Card Game for Pun Lovers

I'll Believe in Anything: The Making of Heated Rivalry Season 1 (The Annotated Scripts)

18 Days in Heaven: I Left My Body. I Met Jesus. What He Told Me Will Alter Your Eternity.

Becoming a Principle-Driven Leader: 41 Principles to Build an Enduring Business

Taylor Swift: Unofficial Search-and-Find Biographies

Saved by the Pack: How 50 Dogs Helped Me Find My Purpose

The Secret Founding of America: The Real Story of Freemasons, Puritans, & the Battle for the New World

The Holistic Guide to Wellness : Herbal Protocols for Common Ailments

JEOPARDY! 2026 Day-to-Day Calendar: Featuring Clues and Responses From America's Favorite Quiz Show®

The Ultimate Book of Facts About Everything: Science, Animals, History, World Records, Inventions, Sports, Pop Culture, Technology, Space, Language, and More!
![Good Lookin' Cookin': A Year of Meals - A Lifetime of Family, Friends, and Food [A Cookbook] by Dolly Parton](https://ecx.images-amazon.com/images/I/81qlpis8AFL._SL300_.jpg)
Good Lookin' Cookin': A Year of Meals - A Lifetime of Family, Friends, and Food [A Cookbook]

The Color of Law: A Forgotten History of How Our Government Segregated America

New Morning Mercies: A Daily Gospel Devotional

I Hope You Remember: Poems on Loving, Longing, and Living

Poop and Learn: Useless Facts for Your Time on the Throne | Funny Toilet Book | Perfect Gag Gift For Curious Minds

Good Energy: The Surprising Connection Between Metabolism and Limitless Health

Supercommunicators: How to Unlock the Secret Language of Connection

The Screaming Goat (Book & Figure) (RP Minis)

The Book of Unusual Knowledge

The Constitution of the United States and The Declaration of Independence

Buy Back Your Time: Get Unstuck, Reclaim Your Freedom, and Build Your Empire

Dogs, Boys, and Other Things I've Cried About: A Memoir

Barbara O’Neill Natural Herbal Remedies Complete Collection: The Ultimate Guide to Knowing ALL of Dr. Barbara O’Neill’s Studies and the Non-Toxic Lifestyle.